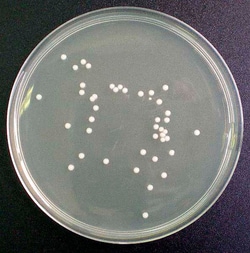
Scharlab Maltextraktagar N 1 Maltextraktagar; Form: Fast | Buy Online | Scharlab | Fisher Scientific

missing translation for 'onlineSavingsMsg'
Läs mer
Läs mer
Scharlab Maltextraktagar Nº 1
Beskrivning
- BAM/KOMPF
- Fast odlingsmedium för isolering och räkning av svampar, med gelatinpepton.
Specifikationer
Specifikationer
| Form | Solid |
| Medietyp | Maltextraktagar |
| Produkttyp | Kulturmedium |
| Formulering | Maltextrakt 13,0 g/l, dextrin 2,5 g/l, gelatinpepton 5,0 g/l, agar 15,0 g/l |
| För användning med (applikation) | Isolering och uppräkning av svampar |
| Inkubationsförhållanden | 20 °C till 25 °C |
| Inkubationstid | ≤5 dagar |
| pH | 5.5± 0,2 |
| Kvantitet | 500 g |
Produkttitel
Genom att klicka på Skicka bekräftar du att du kan bli kontaktad av Fisher Scientific angående feedbacken du har lämnat i detta formulär. Vi kommer inte att dela din information för andra ändamål. All kontaktinformation som tillhandahålls ska också underhållas i enlighet med vår Sekretesspolicy.
Hittar du en möjlighet till förbättring?